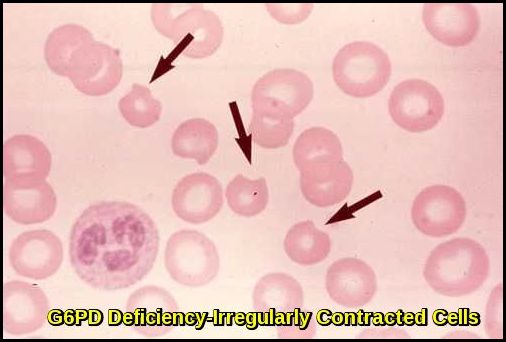
Irregularly contracted red blood cells seen in G6PD deficiency during oxidative haemolysis.

G6PD Deficiency

Global prevalence map of G6PD deficiency, highlighting regions with the highest enzyme deficiency rates.
Introduction:
Glucose-6-phosphate dehydrogenase (G6PD) deficiency is the most common human enzyme disorder, affecting an estimated 400 million people worldwide. Its geographic distribution closely mirrors historical malaria prevalence, supporting the malaria-protection hypothesis. The condition is particularly frequent in individuals from Africa, the Mediterranean region, the Middle East, and Asia. G6PD deficiency is inherited in an X-linked recessive pattern and results from pathogenic variants in the G6PD gene, giving rise to multiple biochemical and clinical phenotypes that influence susceptibility to oxidant-induced haemolysis.
Clinical features:
The most frequent clinical manifestations of G6PD deficiency are neonatal jaundice, and acute hemolytic anemia, which is usually triggered by an exogenous agent. Some G6PD variants cause chronic hemolysis, leading to congenital non-spherocytic hemolytic anemia.
The intermittent hemolysis seen in G6PD deficiency may be provoked by drugs (e.g. Antimalarial drugs, Aspirin & NSAIDs, Nitrofurantoin, Quinidine, Quinine, Sulphonamides), certain foods (such as fava beans), infections or other acute illnesses.
The G6PD Deficiency Association has a more comprehensive online list of medications that people with G6PD deficiency should avoid.

Educational infographic summarizing commonly prescribed medications that may trigger oxidative hemolysis in patients with G6PD deficiency.
In Negroes the disease is self-limiting as reticulocytes have normal enzyme activity; this is not the case in Mediterranean and Oriental varieties.
Investigations:
- Complete blood cell count (FBC) and reticulocyte count.
- Lactate dehydrogenase (LDH) level.
- Indirect and direct bilirubin level.
- Serum haptoglobin level.
- Urinalysis for hematuria.
- Urinary hemosiderin.
- Peripheral blood smear.
- Abdominal ultrasound may be useful in assessing for splenomegaly and gallstones. These complications are typically limited to patients with severe chronic hemolysis.
Irregularly contracted red blood cells characteristic of G6PD deficiency during haemolytic episodes.

Characteristic “blister” RBCs (large arrow) noted in patients with G6PD deficiency are present on this peripheral smear. The pale blue/gray cells (small arrow) are reticulocytes that are increased in response to the hemolytic anemia.
A quantitative analysis of G6PD activity in a leukocyte-depleted sample is definitive. Testing for enzyme activity should be performed when patients are in remission, as results may be falsely negative during acute hemolysis. The reason is that older erythrocytes have been destroyed because their diminished G6PD levels leave them vulnerable to hemolysis while there is a compensatory increase of immature erythrocytes and reticulocytes that have increased G6PD levels.
There is anemia, evidence of intravascular hemolysis (reticulocytosis, raised LDH, raised indirect bilirubin, low serum haptoglobin, fragmented RBCs in peripheral blood smear, and hemoglobinuria/hemosiderinuria), and Heinz bodies in a peripheral smear stained with a supravital stain (note their location in close proximity to cell membrane).

Heinz bodies demonstrating oxidant damage in G6PD deficiency, typically seen during acute haemolysis.

Supravital stain showing Heinz bodies in G6PD deficiency, reflecting oxidative damage to haemoglobin.
Diagnosis:
- There is a simple screening test for G6PD deficiency but care must be taken in Negroes with reticulocytosis to avoid false-negative results.
- G6PD activity is higher in premature infants than in term infants. This should be considered when testing for G6PD deficiency in infants.
- G6PD can also be measured spectrophotometrically and the enzyme detected on electrophoretic gels.
- Screening for G6PD deficiency is indicated in patients with a suggestive family history or in geographical areas with a high prevalence of the disorder.
Treatment:
- This is primarily the avoidance of factors that precipitate hemolysis. Patients should be taught to avoid drugs and chemical exposures that can cause oxidant stress. Patients should also avoid broad beans (ie, fava beans). Favism occurs primarily in the Mediterranean variety of G6PD deficiency.
- Anemia should be treated with appropriate measures, recognizing that hemolysis is self-limited and often resolves in 8 to 14 days.
- Transfusions are rarely indicated.
- Splenectomy is usually ineffective.
- Infants with prolonged neonatal jaundice as a result of G6PD deficiency should receive phototherapy. Exchange transfusion may be necessary in cases of severe neonatal jaundice or hemolytic anemia caused by favism.
- Patients with chronic hemolysis should be placed on daily folic acid supplements.
Summary:
G6PD deficiency is the most common enzymatic disorder of red blood cells, affecting over 400 million people worldwide and inherited in an X-linked recessive pattern. It results from pathogenic variants in the G6PD gene, leading to reduced NADPH generation and vulnerability to oxidative stress. Patients are typically asymptomatic until exposed to oxidative triggers such as infections, certain drugs, or fava beans, which precipitate acute haemolytic episodes characterised by jaundice, dark urine, pallor, and anaemia. Diagnosis is based on haemolysis markers, blood film findings such as blister cells and Heinz bodies, and confirmatory enzymatic assays performed outside the acute phase. Management focuses on trigger avoidance, supportive care during haemolysis, and genetic counselling. Because of its global distribution, particularly in Africa, the Mediterranean, the Middle East, and Southeast Asia, recognising G6PD deficiency is essential for safe prescribing and preventing life-threatening oxidant-induced haemolysis.
Questions and Answers:
What are the common symptoms of G6PD deficiency?
Most individuals remain asymptomatic until exposed to oxidative stress. Symptoms include sudden jaundice, dark urine, fatigue, shortness of breath, and pallor due to acute hemolytic anaemia.
What triggers haemolysis in G6PD deficiency?
The main triggers are bacterial or viral infections, oxidant medications (e.g., sulfa drugs, antimalarials, nitrofurantoin, rasburicase), and ingestion of fava beans. These exposures generate oxidative stress that red cells cannot tolerate due to low G6PD activity.

High-risk medications that may trigger severe hemolysis or methemoglobinemia in patients with G6PD deficiency
How is G6PD deficiency diagnosed?
Diagnosis relies on haemolysis markers (elevated LDH, bilirubin, reticulocytosis), peripheral blood smear abnormalities such as bite cells and Heinz bodies, and a quantitative G6PD enzyme assay. Testing is most accurate when performed after recovery from haemolysis.
Is G6PD deficiency inherited?
Yes. It is an X-linked recessive disorder. Males are typically affected, while females may be carriers or variably affected due to lyonisation.
What foods and medications should be avoided in G6PD deficiency?
Patients must avoid fava beans, certain antimalarials, sulfonamides, nitrofurantoin, dapsone, high-dose aspirin, and other oxidant drugs. A confirmed avoidance list should be provided by healthcare professionals.
Can G6PD deficiency cause chronic anaemia?
Most cases cause episodic haemolysis; however, some severe variants may lead to chronic non-spherocytic haemolytic anaemia requiring ongoing monitoring and specialist care.
How is acute haemolysis managed in G6PD deficiency?
Management includes stopping the trigger, hydration, treating underlying infections, monitoring haemoglobin, and transfusion when necessary. Severe cases may require hospitalisation. Oral folic acid supplementation is also recommended during and after acute haemolysis to support increased erythropoietic demand.
Is rasburicase safe in patients with G6PD deficiency?
No. Rasburicase is contraindicated in G6PD deficiency because it generates hydrogen peroxide during uric acid oxidation, which can trigger severe oxidative haemolysis and life-threatening methemoglobinemia. All patients at risk—particularly those of African, Mediterranean, or Asian ancestry—should be screened for G6PD deficiency before receiving rasburicase for tumour lysis syndrome prophylaxis or treatment.
References:
Nkhoma ET, Poole C, Vannappagari V, Hall SA, Beutler E. The global prevalence of glucose-6-phosphate dehydrogenase deficiency: a systematic review and meta-analysis. Blood Cells Mol Dis. 2009;42(3):267–278.
Luzzatto L, Nannelli C, Notaro R. Glucose-6-phosphate dehydrogenase deficiency. Hematol Oncol Clin North Am. 2016;30(2):373–393.
Frank JE. Diagnosis and management of G6PD deficiency. Am Fam Physician. 2005;72(7):1277–1282.
Lazarchick J. Blister cell – 1. American Society of Hematology Image Bank. Image #00004027. Published March 17, 2014. https://imagebank.hematology.org/image/4027/blister-cell–1
Schick P. Which medications should be avoided in patients with G6PD deficiency-related hemolytic anemia? Medscape. https://www.medscape.com/answers/201066-27087/which-medications-should-be-avoided-in-patients-with-g6pd-deficiency-related-hemolytic-anemia
Keywords:
G6PD deficiency, glucose-6-phosphate dehydrogenase deficiency, G6PD deficiency symptoms, G6PD deficiency diagnosis, G6PD deficiency management, oxidative haemolysis, Heinz bodies, blister cells, bite cells, fava bean hemolysis, favism, hemolytic anemia triggers, oxidant drug hemolysis, rasburicase G6PD deficiency, acute hemolysis treatment, X-linked G6PD deficiency, G6PD variants, Mediterranean G6PD variant, African G6PD A- variant, neonatal jaundice G6PD deficiency, G6PD screening, G6PD enzyme assay, G6PD deficiency complications, red cell oxidative stress, haemolysis in infection, folic acid in hemolysis, Ask Hematologist, Dr Moustafa Abdou


Request Online Consultation With Dr M Abdou
Fee: US$100
Secure payment via PayPal (credit and debit cards accepted)
Pay Now




